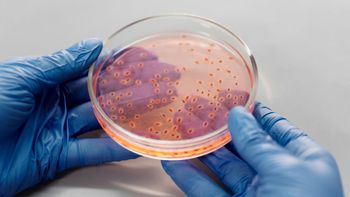

A 21 metros bajo tierra: un estudio revela que estos seres podría purificar toda el agua del planeta
Un estudio reciente plantea una solución natural al desafío urgente de purificar el agua en el planeta Tierra, gracias a diminutos organismos con un gran potencial para proteger nuestros recursos hídricos.